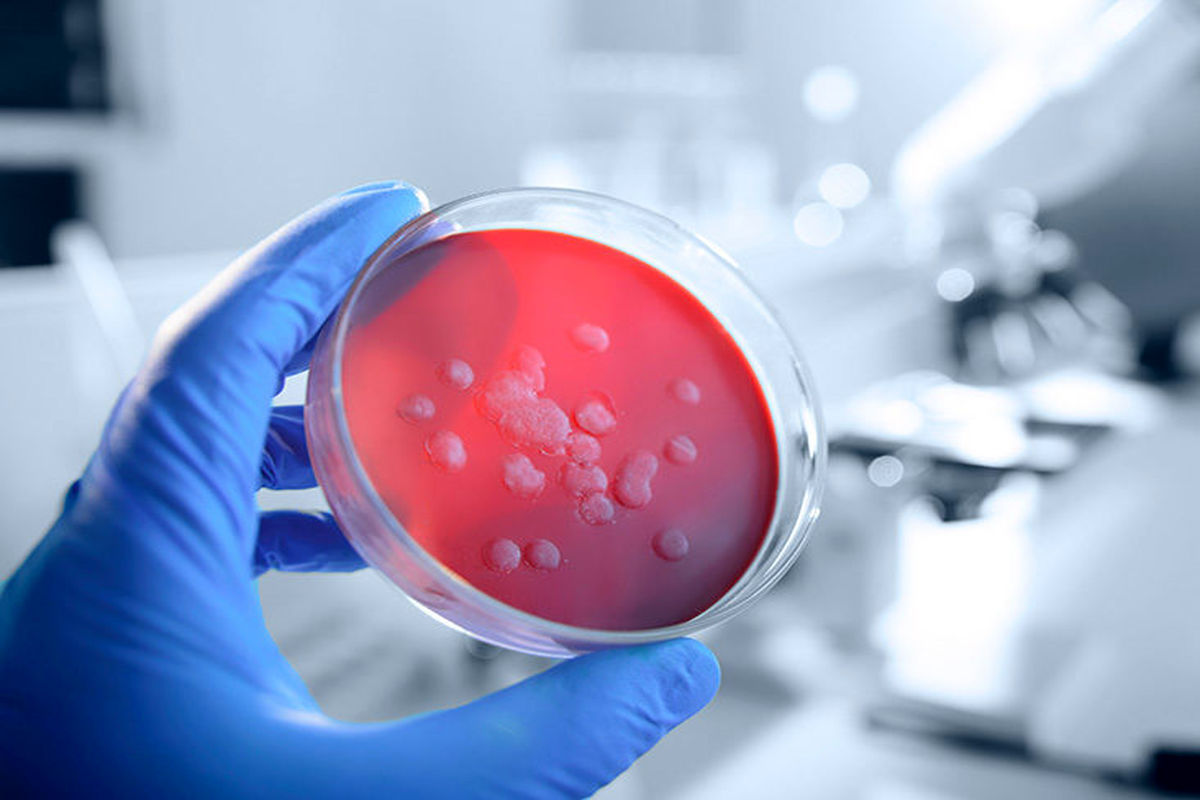
علل بروز عفونت‌های زنانه چیست؟

برچسب - لگن
کارشناسان هشدار میدهند که انداختن پاها روی هم در هنگام نشستن میتواند اثرات نامطلوبی بر سلامتی داشته باشد.
کد خبر: ۱۴۵۴۰۱۲
۱۴۰۲/۰۱/۰۹
محققان دستگاه سونوگرافی جدیدی ساختهاند که علاوه بر سرعت بسیار بالا، دقت اعجاب آوری هم دارد همچنین از امکان تشخیص بیماریهای بسیار مهمی برخوردار است.
کد خبر: ۱۴۴۹۶۲۶
۱۴۰۱/۱۲/۲۵
رئیس انجمن متخصصین زنان و زایمان ایران با اشاره به اینکه اکثر عفونت های واژینال با استفاده از توصیه های پزشکی و مصرف دارو بعد از معاینه توسط پزشک قابل درمان هستند، گفت: در صورتیک اقدام درمانی ای صورت نگیرد می تواند منجر به بیماری التهابی لگن ، ناباروری، زایمان زودرس و سقط جنین شوند.
کد خبر: ۱۳۶۹۸۴۲
۱۴۰۱/۰۶/۰۷
نتایج یک مطالعۀ جدید نشان میدهد، بانوانی که گوشت مصرف نمیکنند در سنین بالا در معرض خطر جدی شکستگی لگن قرار دارند
کد خبر: ۱۳۶۳۴۸۳
۱۴۰۱/۰۵/۲۳
عضو هیئت علمی بیمارستان آیت الله طالقانی به زنان هشدار داد که اختلالات کف لگن یا بیاختیاری ادراری را جدی گرفته و با مراجعه به پزشک متخصص برای درمان و کاهش عوارض آن اقدام کنند.
کد خبر: ۱۱۴۶۶۶۷
۱۳۹۹/۱۲/۱۳